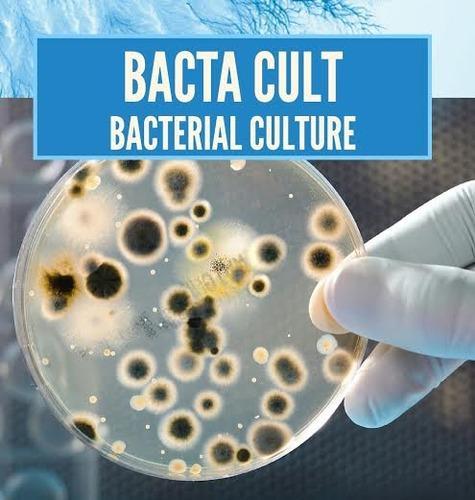

Ever since our inception in the year
2005, we,
"Rajasthan Forging Works" have been concerned in providing the most reliable and consistent services to the clients. We are engaged in providing valuable services to our esteemed clients in the area of specialist in Pipe Bending Job Works, Pipe Bending Job Works, Flange Bending Job Works, Plate Bending Job Works etc. with high quality standards and commitment to customer satisfaction.
Our professionals are working very hard to achieve the desired productivity. We are supported by a well connected logistic network to deliver the offered products on time at client premises.
Under the valuable supervision of our mentor Mr. Altaf Kazi, we have carved this reputation in the industry. His vast industry experience and rich domain knowledge enable us to offer an optimum level of customer satisfaction.
We have developed a highly advanced testing unit for same purpose.
We have developed a highly advanced testing unit for same purpose. We have installed all the modern testing tools required for the inspection of the provided products. We have recruited a team of talented and well qualified professionals to handle our business operations.